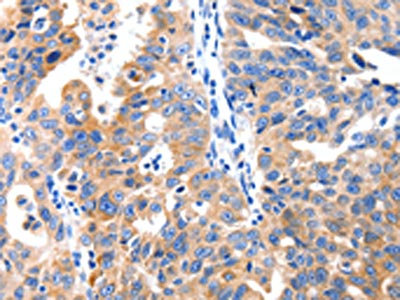

-
中文名稱:GRM1兔多克隆抗體
-
貨號:CSB-PA559950
-
規格:¥1100
-
圖片:
-
The image on the left is immunohistochemistry of paraffin-embedded Human colon cancer tissue using CSB-PA559950(GRM1 Antibody) at dilution 1/10, on the right is treated with synthetic peptide. (Original magnification: ×200)
-
The image on the left is immunohistochemistry of paraffin-embedded Human ovarian cancer tissue using CSB-PA559950(GRM1 Antibody) at dilution 1/10, on the right is treated with synthetic peptide. (Original magnification: ×200)
-
-
其他:
產品詳情
-
Uniprot No.:
-
基因名:
-
別名:Glutamate receptor metabotropic 1 antibody; glutamate receptor; metabotropic 1 antibody; GPRC1A antibody; GRM1 antibody; GRM1-Alpha antibody; GRM1_HUMAN antibody; GRM1A antibody; Metabotropic glutamate receptor 1 antibody; mGlu1 antibody; mGluR1 antibody; MGLUR1-Alpha antibody; MGLUR1A antibody; SCAR13 antibody
-
宿主:Rabbit
-
反應種屬:Human,Mouse,Rat
-
免疫原:Synthetic peptide of Human GRM1
-
免疫原種屬:Homo sapiens (Human)
-
標記方式:Non-conjugated
-
抗體亞型:IgG
-
純化方式:Antigen affinity purification
-
濃度:It differs from different batches. Please contact us to confirm it.
-
保存緩沖液:-20°C, pH7.4 PBS, 0.05% NaN3, 40% Glycerol
-
產品提供形式:Liquid
-
應用范圍:ELISA,IHC
-
推薦稀釋比:
Application Recommended Dilution ELISA 1:1000-1:2000 IHC 1:10-1:50 -
Protocols:
-
儲存條件:Upon receipt, store at -20°C or -80°C. Avoid repeated freeze.
-
貨期:Basically, we can dispatch the products out in 1-3 working days after receiving your orders. Delivery time maybe differs from different purchasing way or location, please kindly consult your local distributors for specific delivery time.
-
用途:For Research Use Only. Not for use in diagnostic or therapeutic procedures.
相關產品
靶點詳情
-
功能:G-protein coupled receptor for glutamate. Ligand binding causes a conformation change that triggers signaling via guanine nucleotide-binding proteins (G proteins) and modulates the activity of down-stream effectors. Signaling activates a phosphatidylinositol-calcium second messenger system. May participate in the central action of glutamate in the CNS, such as long-term potentiation in the hippocampus and long-term depression in the cerebellum. May function in the light response in the retina.
-
基因功能參考文獻:
- Age-dependent increase in metabotropic glutamate receptor type 1 availability in several brain regions may exist predominantly in males. PMID: 28431287
- Missense Mutation in GRM1 gene is associated with Spinocerebellar Ataxia Type 44. PMID: 28886343
- our findings suggest that pharmacological manipulation of mglur1 should be explored as an exciting new approach for the treatment of a variety of human cerebellar ataxias. PMID: 26748626
- a missense variant was found in GRM1 gene, while in the second family, a frameshift alteration was identified in TRMT1, both of which were found to co-segregate with the intellectual disability. PMID: 26308914
- It has the intrinsic ability to form a heteromeric complex with adenosine A1 receptor and mutually modulate signaling. PMID: 26154847
- These data demonstrate that the approaches commonly used to study mGlu1 receptor function and signaling in other systems may be inappropriate for studying mGlu1 receptor-mediated melanoma cell viability. PMID: 26291396
- Our results are likely relevant to human breast cancer, highlighting a putative role of mGluR1 in the pathophysiology of breast cancer and the potential of mGluR1 as a novel therapeutic target. PMID: 25859923
- elevated glutamate secretion and mGluR1 expression play a role in Kaposi's sarcoma associated herpesvirus induced cell proliferation PMID: 25299066
- alpha-actinin-4 is a novel group 1 mGluR-interacting partner that orchestrates spine dynamics and morphogenesis in neurons. PMID: 25944910
- These novel mutations may contribute to the disease by alterations in GRM1 gene splicing, receptor activation, and post-receptor downstream signaling. PMID: 25062106
- Results suggest a role for mGluR1 in breast cancer as a pro-angiogenic factor as well as a mediator of tumor progression. PMID: 24633367
- In mice expressing mutant beta-III spectrin, mGluR1 localization is altered at Purkinje cell dendritic spines. PMID: 25057192
- mGluR1 cooperates with other factors in hyperplastic mammary epithelium to contribute to TNBC progression PMID: 24404125
- reflected in the immunoblotting data Mglur1 receptors were detected at higher levels of expression in patient with cortical dysplasia with intractable epilepsy. PMID: 25003238
- GRM1 activation triggers proangiogenic signaling in melanoma. PMID: 24491800
- GRM1 is upregulated through gene fusion and promoter swapping in chondromyxoid fibroma. PMID: 24658000
- mGluR1-dependent synaptic transmission in the cerebellum is regulated by STIM1 in neuronal Ca(2) signaling. PMID: 24811382
- These findings suggest a functional role for GRM1 in breast cancer. PMID: 23922822
- structure determined of the mGlu1 receptor seven-transmembrane (7TM) domain bound to a negative allosteric modulator, FITM, at a resolution of 2.8 angstroms PMID: 24603153
- During ischemia, mGluR1 activation improves cortical astrocytes and GABAergic neurons. PMID: 23109136
- Extracellular calcium modulates actions of orthosteric and allosteric ligands on metabotropic glutamate receptor 1alpha PMID: 24280223
- It regulates synaptic response, exitability of neurons and secretion of neurotransmitters. (review) PMID: 24334926
- mGluR1 recruitment to lipid rafts is enhanced by agonist binding and is supported at least in part by an intact cholesterol recognition/interaction amino acid consensus (CRAC) motif in the receptor. PMID: 24045944
- Grm1 indeed can be oncogenic in epithelial cells and can activate the multiple characteristic cancer-signaling pathways-and that components of the glutamatergic system are active in RCC. PMID: 23085756
- Suppression of GRM1 expression in several human melanoma cell lines resulted in a reduction in the number of viable cells and a decrease in stimulated mitogen-activated protein kinase (MAPK) and PI3K/AKT and suppressed tumor progression in vivo. PMID: 22798429
- This new splice variant, mGlu1h receptor, is encoded by two previously unidentified exons located within the human GRM1 gene, and these new exons are found exclusively within the GRM1 genes of higher primates and are highly conserved. PMID: 23481697
- Somatic mutations in mGluR1a disrupt signaling in cancer with multiple downstream consequences. PMID: 23303475
- demethylation within the promoter region of GRM1 may also be a mechanism for the derepression of mGluR1 expression in melanocytes that progress to cell transformation and tumor formation. PMID: 22771868
- These experiments provide us with an understanding of the role Rabs play in coordinated regulation of mGluR1a and how this impacts mGluR1a signaling PMID: 23175844
- Only a single subunit assumes an active state in an mGluR1 receptor dimer. PMID: 22894836
- The study implicates mGluR1 in human hereditary ataxia. PMID: 22901947
- Normal, non-mutated CFTR, as well as mutated forms of CFTR were associated with metabotropic mGluR1. PMID: 22520513
- Deleterious GRM1 mutations are associated with schizophrenia. PMID: 22448230
- This study demonistrated that childhood-onset mood disorders and suicide attempt association between HOMER1 rs2290639 and between NPTX2 markers rs705315 and rs1681248. PMID: 22460132
- Within the GRM1 locus, 22 SNPs showed nominally significant association with UPD, of which 6 withstood corrections for multiple testing. PMID: 21962378
- Observations implicate mGluR1 and glutamate signaling as a promising new molecular target for the treatment of breast cancer. PMID: 21681448
- These data indicate group I mGluRs are highly expressed on oligodendrocytes during the peak period of vulnerability to HI and modulation of mGluRs is protective in a rodent model of periventricular leukomalacia. PMID: 22169210
- Disruption of mGluR1 signaling at parallel fiber-Purkinje cell synapses is a major synaptic defect in homozygous staggerer mice, correlating with spinocerebellar ataxia (SCA) type 1 pathology in the extreme mouse model. PMID: 21558162
- analysis of clustered coding variants in the glutamate receptor complexes of individuals with schizophrenia and bipolar disorder PMID: 21559497
- Studies indicate that FXS has been linked to altered group I metabotropic glutamate receptor (mGluR)-dependent, and potential targeted therapeutic strategies developed to specifically correct disturbances in the excitatory mGluR. PMID: 20864408
- Elucidation of a novel extracellular calcium-binding site on metabotropic glutamate receptor 1{alpha} (mGluR1{alpha}) that controls receptor activation. PMID: 20705606
- These findings show a differential expression pattern of mGluR1a and mGluR5, suggesting a role for both receptors in the early stages of corticogenesis with, however, a different contribution to human cortical developmental events. PMID: 20149785
- Absence of mutations in a relatively small cohort of patients appears to suggest that mutations in GRM1 are not frequent in cerebellar ataxias. PMID: 19924463
- Taken together, these results showed that, in addition to the MAPK pathway previously reported being a downstream target of stimulated Grm1, AKT2 is another downstream target in Grm1 mediated melanocyte transformation. PMID: 19843246
- In patients with mesial temporal lobe epilepsy, mGluR1 may increase hippocampal excitability through postsynaptic activation. PMID: 11951051
- internalization of mGluR1 splice variants is subject to PKC and CaMKII regulation. PMID: 11961129
- identification of crucial residues for setting the activated state PMID: 12444084
- Melanoma model implicates metabotropic glutamate signaling in melanocytic neoplasia. PMID: 12704387
- PKA activation inhibits the agonist-induced internalization and desensitization of mGluR1a and mGluR1b, probably by reducing their interaction with GRK2 and nonvisual arrestins. PMID: 15155843
- metabotropic glutamate receptors 1 and 5 mediate opposite glutamate effects in human lymphocyte activation PMID: 15184389
顯示更多
收起更多
-
相關疾病:Spinocerebellar ataxia, autosomal recessive, 13 (SCAR13); Spinocerebellar ataxia 44 (SCA44)
-
亞細胞定位:Cell membrane; Multi-pass membrane protein.
-
蛋白家族:G-protein coupled receptor 3 family
-
組織特異性:Detected in brain.
-
數據庫鏈接:
Most popular with customers
-
YWHAB Recombinant Monoclonal Antibody
Applications: ELISA, WB, IHC, IF, FC
Species Reactivity: Human, Mouse, Rat
-
-
-
-
-
-
-